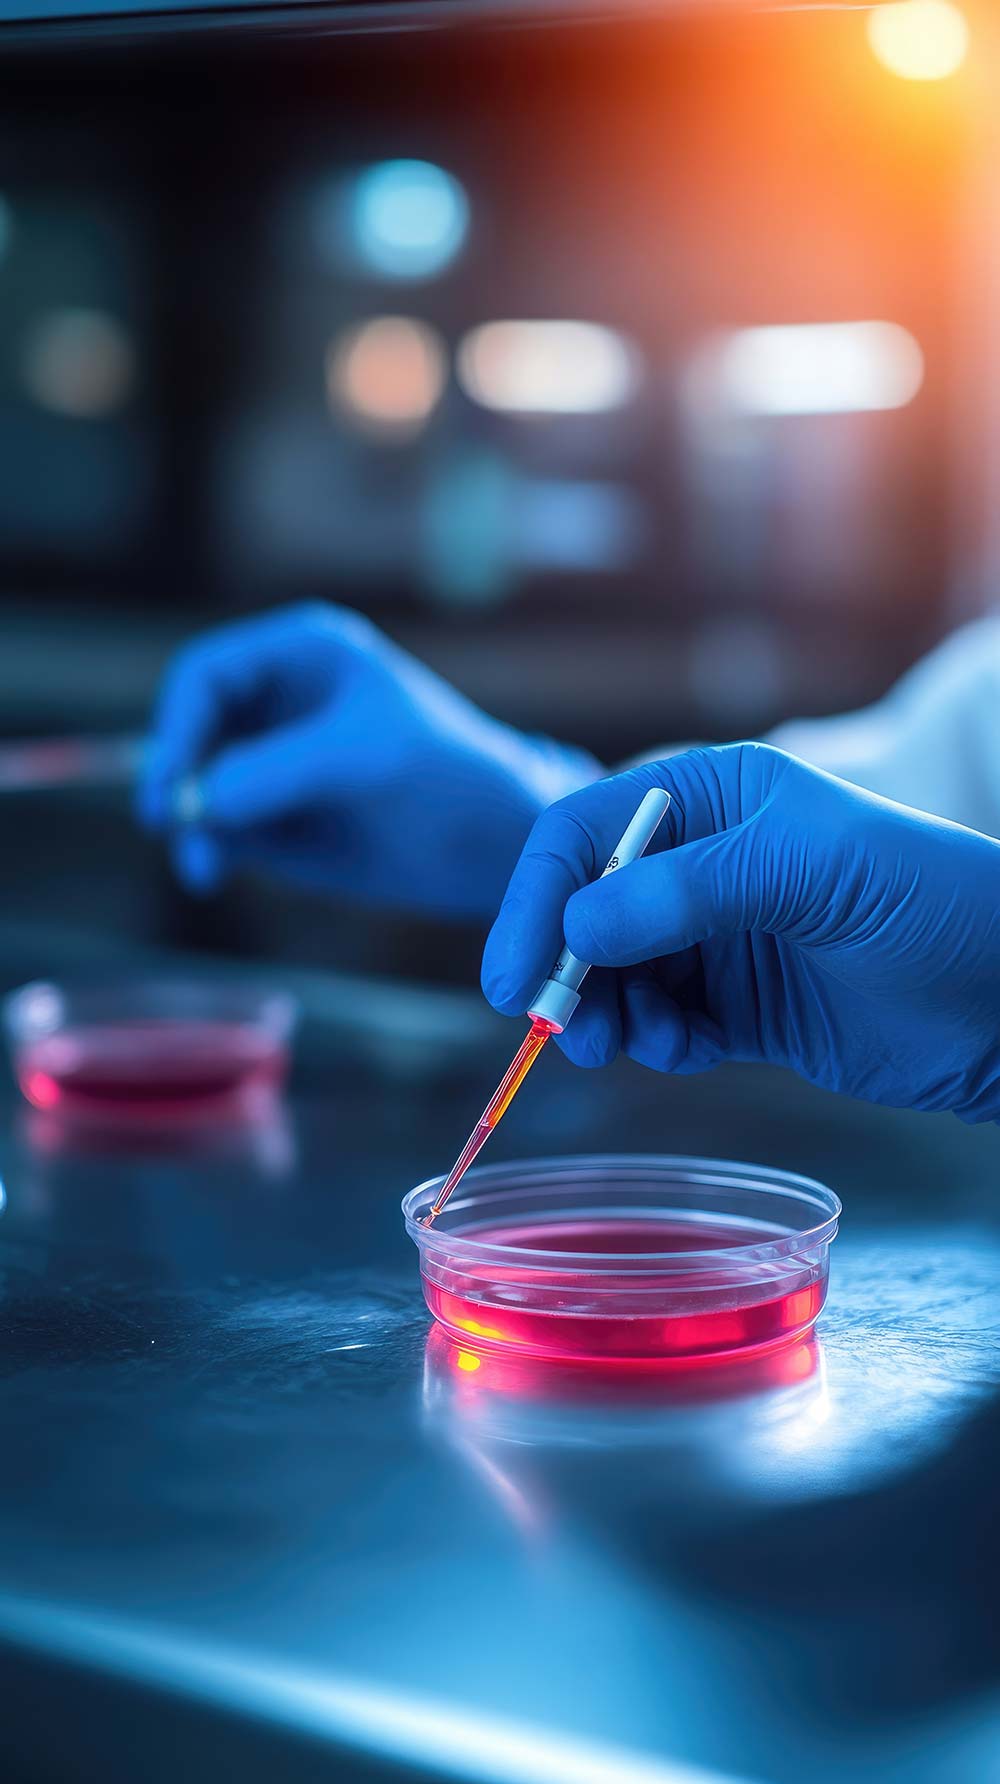
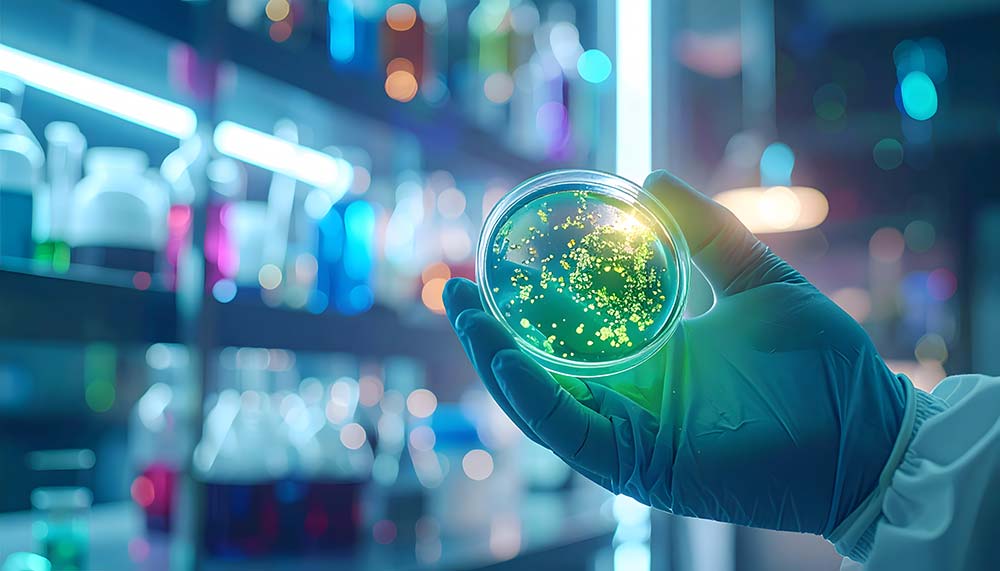

未来实验室
AI菌群检测仪
读懂皮肤“微生物密码”
2026年03月04日 04:38
当我们还在凭肤质标签挑选护肤品,为反复出现的敏感、出油、长痘束手无策时,皮肤微生态领域的研究早已揭示了护肤的核心真相:健康肌肤的底色,藏在表层那片看不见的“微生物森林”里。这片森林中,200余种有益菌株相互制衡、协同作用,构成维持皮肤屏障的动态平衡网络,而菌群失衡正是诸多皮肤问题的根源所在。如今,随着AI技术与微生物检测技术的跨界融合,一款未来家用AI菌群检测仪正悄然走来,有望让普通人足不出户读懂皮肤“微生物密码”,彻底告别“盲目护肤”,推动个性化护肤从“凭感觉”走向“靠数据”。


这款备受期待的家用AI菌群检测仪,核心优势在于将专业实验室的微生态检测技术平民化、便捷化,其功能设定并非空中楼阁,而是建立在现有成熟技术的基础上,具备充分的实现可能性。据了解,该设备体积小巧便携,无需专业操作技能,普通人即可独立完成检测——仅需用专用采集拭子轻刮皮肤表层,完成无创取样后,将样本放入设备,搭配内置的AI算法,5分钟内就能生成完整的皮肤微生态报告,清晰告知用户“有益菌是否不足”“有害菌是否超标”,并根据检测结果推荐适配的个性化护肤方案。
其技术可行性,可从检测技术、AI算法两大核心维度,结合当前行业研究成果得到充分验证。在检测技术层面,设备的核心突破的是简化了专业实验室的菌群测序流程,却保留了核心检测逻辑。专业实验室常用的宏基因组测序、16S rRNA测序等技术,已能精准识别皮肤微生物的种类与丰度,而随着测序技术的普及与成本降低,将其小型化、家用化已具备现实条件。微基生物的皮肤微生物采集研究显示,通过专用拭子对皮肤表层进行规范取样,无需复杂操作即可获取足够的微生物样本,且采用常温保存液技术,可实现样本的常温保存与检测,无需低温存储设备,这为家用设备的便捷性提供了技术支撑——未来家用AI菌群检测仪可直接沿用这种无创取样方式,优化取样流程,确保普通用户也能规范操作,获取合格样本。
在AI算法层面,其精准度的核心支撑是海量菌群数据的训练积累。当前,皮肤微生物研究已积累了庞大的数据库,仅美国肠道计划、curatedMetagenomicData数据库就收录了数万份皮肤、肠道等部位的微生物测序样本,为AI模型的训练提供了充足的数据基础。未来家用AI菌群检测仪的算法,可基于这类成熟技术进行优化,专门针对常见皮肤问题与菌群失衡类型进行训练,实现两者的精准匹配,这一点已得到行业实践印证——美国Milieu公司已推出家用皮肤菌群检测套装,通过拭子取样、AI分析,可生成个性化护肤建议,其核心技术逻辑与这款未来设备高度一致,证明了家用AI菌群检测的可行性。

尽管技术可行,但消费者最关心的两大实用疑问仍需严谨回应,这也是家用设备能否落地的关键。第一个疑问:家用设备的检测精度能否媲美专业实验室?对此,行业研究给出了客观答案:目前家用微生物检测设备的精度虽未完全达到专业实验室水平,但已能满足日常护肤的需求。需要明确的是,专业实验室的检测更侧重科研、临床诊断,需对微生物进行全面、深度测序,而家用设备聚焦“日常护肤指导”,简化了部分测序流程,重点检测与皮肤问题密切相关的核心菌群,其精度完全能支撑个性化护肤方案的制定,无需追求与专业实验室的“全维度一致”。
第二个疑问:如何避免取样操作不当影响结果?这一问题可通过技术优化和操作指引双重解决。微基生物的皮肤微生物采集研究明确了规范取样的核心要点:取样前12小时内不使用清洁用品、护肤品,取样时保持拭子与皮肤适度贴合,按规范区域擦拭,即可获取合格样本。未来家用AI菌群检测仪可针对性优化设计:搭配一次性无菌专用拭子,避免污染。设备内置操作提示,通过语音、灯光引导用户规范取样。同时,AI算法可对样本质量进行初步判断,若取样不合格,将及时提醒用户重新取样,从源头降低操作不当的影响。此外,设备可联动手机APP,实时更新取样指引和注意事项,进一步提升操作的规范性。
这款设备的落地价值,远不止“便捷检测”,更在于推动护肤行业的范式革新,让微生态检测走进日常,重构普通人的护肤逻辑。长期以来,个性化护肤多停留在“按肤质分类”的层面,无法精准匹配每个人的皮肤微生态差异,导致很多人“用对了护肤品,却没改善皮肤问题”。而皮肤微生态的核心特点是“动态变化”,会受饮食、作息、环境、护肤品等因素影响,呈现动态波动。家用AI菌群检测仪可实现“动态监测”,用户可定期检测皮肤菌群状态,通过手机APP查看菌群变化趋势,设备根据变化自动更新护肤建议,帮助消费者动态调整护肤方案,实现“千人千面、按需护肤”。

从行业层面来看,这款设备的落地将推动护肤行业从“成分导向”向“微生态导向”升级。未来,随着家用AI菌群检测仪的普及,更多消费者将意识到微生态的重要性,倒逼护肤品企业加大微生态相关产品的研发,推出更贴合不同菌群状态的益生菌、益生元类护肤品,形成“检测-调理-监测”的完整护肤闭环。随着技术的不断优化,设备的检测精度将进一步提升,成本将逐步降低,有望成为未来家用护肤的“标配”。
当AI读懂皮肤的微生物密码,当护肤从“盲目尝试”走向“数据驱动”,我们终于有望摆脱护肤内耗,真正实现“对症护肤”。这款未来家用AI菌群检测仪的出现,不仅是技术跨界的成果,更是护肤理念的升级——它让我们明白,健康的肌肤,从来不是“养出来的”,而是“平衡出来的”。相信在不久的将来,每个人都能通过这款小小的设备,读懂自己的皮肤微生态,拥有专属的护肤方案,让“精准护肤”不再是奢侈品,而是触手可及的日常。
本文由中国香妆融媒体/中国美肤科学传播平台Bioπ苗苗撰写,同时参考了公开资料和报道,如有疏漏或偏差之处,敬请指正。Bioπ中国美肤科学传播平台发布本文只是为了更多的信息参考,不代表任何有倾向性的投资意见或市场暗示。
THE END

京公网安备11010502058609号





















